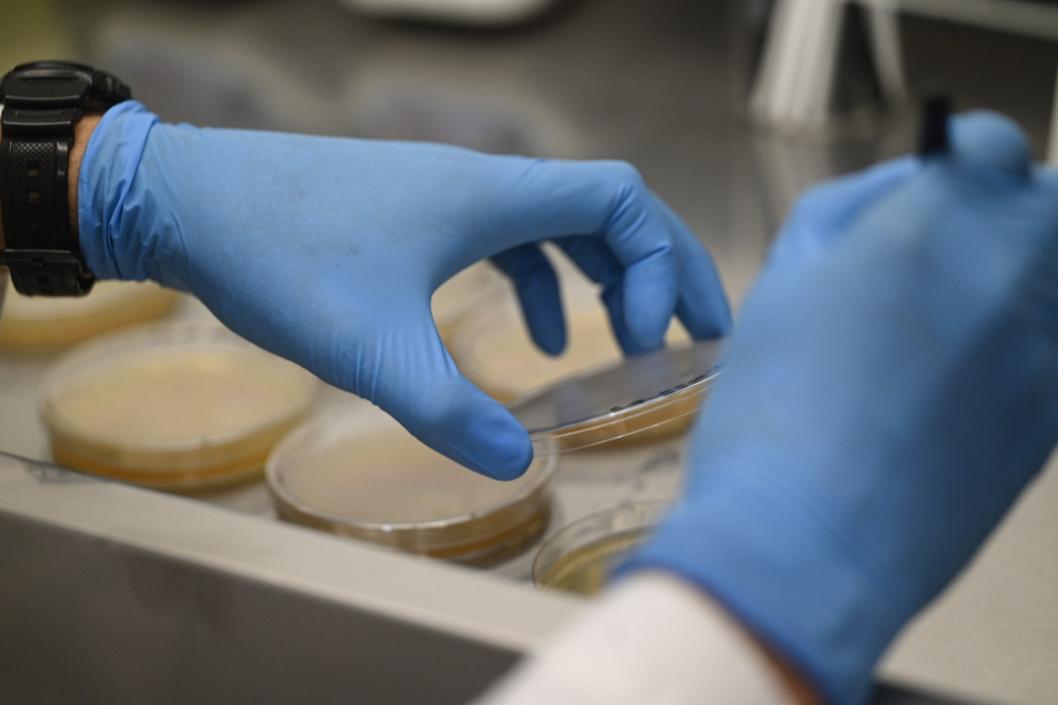

Тюменские аграрии получат субсидии на поддержку элитного семеноводства
| Фото: Сергей Елесин, ИА "Тюменская линия"
| Фото: Сергей Елесин, ИА "Тюменская линия"
Тюменским сельхозпроизводителям возместят часть затрат на поддержку элитного семеноводства.
Субсидия выплачивается по ставке на одну тонну приобретенных элитных либо оригинальных семян: картофель - 3 тыс. рублей, овощные культуры, включая гибриды, - 10 % от суммы затрат на каждую тонну.
В случае приобретения семян, произведенных в рамках федеральной научно-технической программы развития сельского хозяйства на 2017 - 2030 годы, субсидия предоставляется по ставке в размере 70 % от затрат на покупку, сообщает региональный департамент агропромышленного комплекса.
Заявки принимают со 2 по 12 июня. Подробности здесь.






